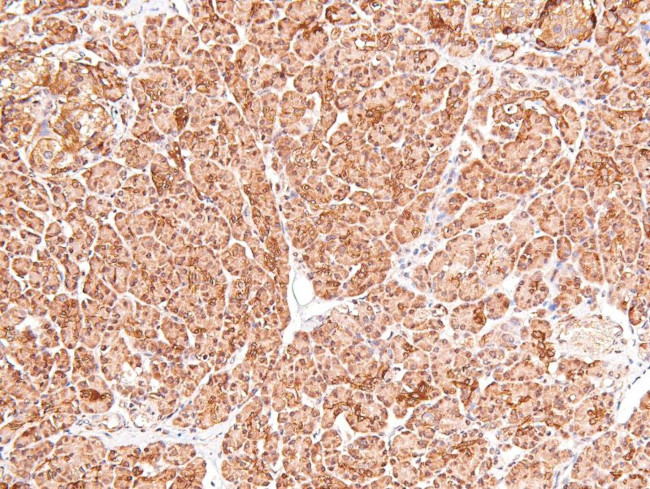
Phospho-cGKII (Ser126) Antibody in Immunohistochemistry (Paraffin) (IHC (P))

Search
Invitrogen
Phospho-cGKII (Ser126) Polyclonal Antibody
{{$productOrderCtrl.translations['antibody.pdp.commerceCard.promotion.promotions']}}
{{$productOrderCtrl.translations['antibody.pdp.commerceCard.promotion.viewpromo']}}
{{$productOrderCtrl.translations['antibody.pdp.commerceCard.promotion.promocode']}}: {{promo.promoCode}} {{promo.promoTitle}} {{promo.promoDescription}}. {{$productOrderCtrl.translations['antibody.pdp.commerceCard.promotion.learnmore']}}
图: 1 / 4
Phospho-cGKII (Ser126) Antibody (PA5-118661) in IHC (P)




产品信息
PA5-118661
宿主/亚型
分类
类型
抗原
偶联物
形式
浓度
保存条件
运输条件
RRID
靶标信息
PRKG2 (PKG2, cGKII) exhibits many cellular functions and has cAMP- and cGMP-dependent protein kinase activity. cGKII is thought to play a key role in a diverse set of physiological pathway. cGKII may mediate intestinal secretion of water and electrolytes induced by the E. coli toxin STa and the intestinal peptide guanylin. Identification of the pathway that mediates intestinal fluid secretion by E. coli. cGKII is postulated to be a molecular switch that couples the cessation of proliferation and the start of hypertrophic chondrocyte differentiation through attenuating SOX9 function.
仅用于科研。不用于诊断过程。未经明确授权不得转售。